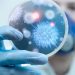
DSÖ: Kovid-19 küresel acil durumu sona erdi

Artı Gerçek – Millet İttifakı Cumhurbaşkanı Adayı ve CHP lideri Kemal Kılıçdaroğlu, eşi Selvi Kılıçdaroğlu’nun Twitter paylaşımını retweet ederek duygu yüklü bir paylaşım yaptı.
Selvi Kılıçdaroğlu, bugünün doğum günü olduğunu belirttiği sosyal medya paylaşımında, “Ömrünü devlete ve siyasete vermiş biriyle hayatı paylaşmak zordur, hep özlersiniz, çocuklarınız özler. Bugün benim doğum günüm. ????” ifadelerine yer verdi. Paylaşımda ayrıca bir de Kemal Kılıçdaroğlu ile bir görüntülü konuşmadan video kesit yer aldı.
Bunun ardından eşinin paylaşımını retweet eden Kemal Kılıçdaroğlu, şu notu düştü:
“Hayat arkadaşım, derttaşım, yuvamızın Selvi’si. Ne dese haklıdır.”
Hayat arkadaşım, derttaşım, yuvamızın Selvi’si. Ne dese haklıdır. https://t.co/Lm88MfCXxH
— Kemal Kılıçdaroğlu (@kilicdarogluk) May 5, 2023
(HABER MERKEZİ)
Selahattin Demirtaş’tan Kemal Kılıçdaroğlu ve Yeşil Sol için oy çağrısı
Kılıçdaroğlu Der Spiegel’e konuştu: Erdoğan’ın söyleyecek yeni bir şeyi kalmadı
Takipçisi azalan tek aday İnce, en çok takipçi artışı Kılıçdaroğlu’nda
Kaynak: Artı Gerçek
***Mutluluk, adalet, özgürlük, hukuk, insanlık ve sevgi paylaştıkça artar***